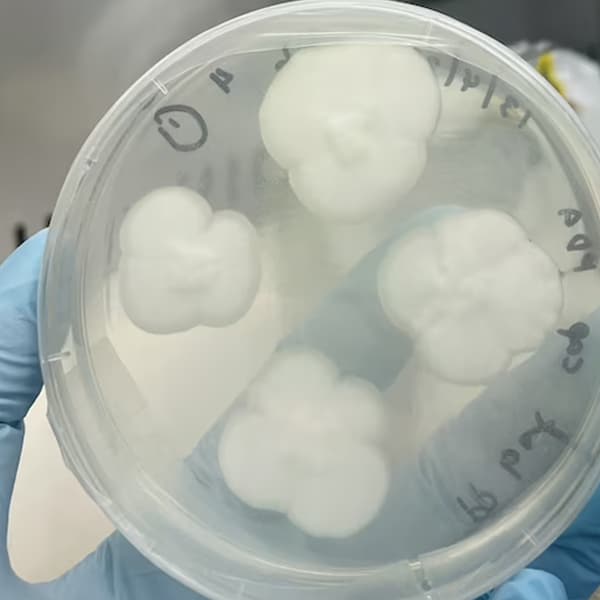

Will Lahaina’s 150-Year-Old Banyan Tree Survive the Devastating Maui Wildfires?
The Hawaiian island of Maui is dealing with one of the biggest disasters in its history. As of August 14, the deadly wildfires continue to ravage the island. According to CNN, the death toll has risen to 99, with hundreds of people still unaccounted for. On top of the tragic loss of life and the people who have sadly lost everything, the cultural heritage of Hawai'i has also taken a massive blow.